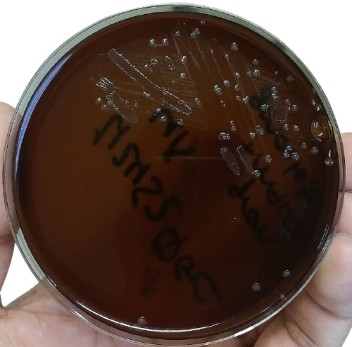
Neisseria gonorrhoeae in New York City Medium - Neisseria gonorrhoeae in New York City Medium(Imagesource)

New York City agar base was developed initially by Fauer, Weisburd, and Wilson at the New York City Department of Health for selective isolation of pathogenic Neisseria species from clinical specimens.
New York City (NYC) medium is primarily designed to isolate pathogenic Neisseria. It also supports the growth of genital mycoplasmas (Mycoplasma hominis and Ureaplasma urealyticum). New York City (NYC) medium is helpful in the diagnosis of gonorrhea and recognition of active or asymptomatic mycoplasma infections. It is a transparent medium.
Principle
NYC medium consists primarily of peptone-corn starch agar-base buffered with phosphates and supplemented with horse plasma, horse hemoglobin, dextrose, yeast autolysate, and antibiotics. The transparent nature of the medium helps in studying the colonial types.
- Protease peptone, horse plasma, and hemoglobin provide nutrientsfor the growth of N. gonorrhoeaeand N. meningitides.
- Phosphate buffers the medium.
- The selective supplementadded contains the antibiotics vancomycin (to inhibit gram-positive bacteria), colistin (to inhibit gram-negative bacilli), nystatin (to inhibit yeast), and trimethoprim. Colistin inhibits gram-negative bacteria, including Pseudomonas species, while Proteus is inhibited by trimethoprim. The combination of trimethoprim and colistin acts synergistically against gram-negative bacilli.
- Starch neutralizes the toxic metabolites produced by Neisseria.
- The yeast autolysatesupplement fulfills the CO2 requirements needed to enhance Neisseria growth. Yeast contains oxaloacetic acid, which is metabolized by gonococci to produce sufficient CO2 for the growth of capnophilic gonococci. Also, yeast autolysate’s presence reduces Neisseria‘s lag phase, thus enhancing both the size and number of colonies.
The specimen can be directly streaked on the medium to obtain maximum isolation.**
Composition of New York City medium agar base
Final pH ( at 25°C) 7.4±0.2
| Ingredients | Gms / Litre |
|---|---|
| Proteose peptone | 15.0 |
| Corn starch | 1.0 |
| Glucose | 5.0 |
| Sodium chloride | 5.0 |
| Dipotassium hydrogen phosphate | 4.0 |
| Potassium dihydrogen phosphate | 1.0 |
| Agar | 20.0 |
Procedure for the preparation of New York City medium
- Suspend 25.50 grams in 320 ml distilled water.
- Heat to boiling to dissolve the medium completely.
- Sterilize by autoclaving at 15 lbs pressure (121°C) for 15 minutes. Avoid overheating.
- Cool to 45-50°C and add aseptically 100 ml of sedimented horse blood cells and 60 ml of citrated horse plasma along with rehydrated contents of 1 vial of NYC Supplement and 1 vial of yeast autolysate supplement.
- Mix well and pour into sterile Petri plates.
Limitation and recommendation
- Some strains of N. gonorrhoeae are inhibited by the concentration of vancomycin in the selective media, so the addition of nonselective chocolate agar is recommended, especially in suspect cases that are culture negative or for sterile specimens (e.g., joint fluid)
References
- Madigan Michael T, Bender, Kelly S, Buckley, Daniel H, Sattley, W. Matthew, & Stahl, David A. (2018). Brock Biology of Microorganisms (15th Edition). Pearson.
- Color Atlas and Textbook of Diagnostic Microbiology, Koneman, 5th edition
- Bailey & Scott’s Diagnostic Microbiology, Forbes, 11th edition
- Faur, Y. C., Weisburd, M. H., Wlson, M. E., & May, P. S. (1974). NYC medium for simultaneous isolation of Neisseria gonorrhoeae, large-colony mycoplasmas, and T-mycoplasmas. Applied microbiology, 27(6), 1041–1045. https://doi.org/10.1128/am.27.6.1041-1045.1974